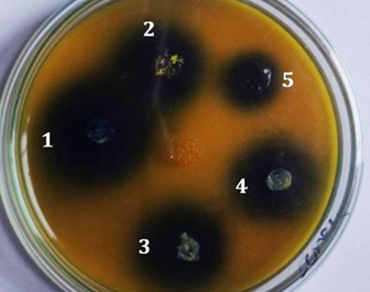
ACCD, Exopolysaccharides, Drought resistant, Heat resistant, α-ketobutyrate

Improved Zea mays L production using heat resistant, drought tolerating ACC deaminase producer Bacillus subtilis
*Article not assigned to an issue yet
Patil Satish V., Mohite Bhavana V., Koli Sunil H., Patil Vikas S., Pulidindi Indra Neel, Kamalja Kirtee K.
Research Articles | Published: 08 April, 2026
First Page: 0
Last Page: 0
Views: 440
Keywords: ACCD, Exopolysaccharides, Drought resistant, Heat resistant, α-ketobutyrate
Abstract
Screening of heat tolerant bacterial species for 1-amino-cyclopropane-1-carboxylate deaminase (ACC deaminase) and exopolysaccharides producing potential was demonstrated, which help to reduce drought stress in crop plants. Among the screened isolates, Bacillus subtilis SV1 was found to be a heat-resistant bacterium with the ability to confer drought tolerance in plants and enhance plant growth in the specific instance of Zea mays (maize). The enhancement in crop productivity is attributed to the unique potential of Bacillus subtilis SV1 to produce ACC deaminase and exopolysaccharides. The isolate demonstrated the ability not only to grow at elevated temperatures (40–50 °C) but also under artificially created higher osmotic pressures, with significant production of ACC deaminase, which significantly enhanced germination and plant height by 25.25% while crop yield by 29.65%. Bacillus subtilis SV1 is thus a promising candidate for the preparation of bioinoculants used in drought prone areas to enhance crop yields.
References
Abdelaal K, AlKahtani M, Attia K, Hafez Y, Király L, Künstler L (2021) The role of plant growth-promoting bacteria in alleviating the adverse effects of drought on plants. Biology 10:520. https://doi.org/10.3390/biology10060520
Alban LA, Mildred K (1959) Methods of soil analysis as used in the OSC soil testing laboratory OSC soil testing laboratory pp.2–15
Bajaj I, Singhal R (2011) Poly (glutamic acid) – An emerging biopolymer of commercial interest. Bioresour Technol 102:s5551–5561. https://doi.org/10.1016/j.biortech.2011.02.047
Bal SK, Minhas PS (2017) Atmospheric stressors: challenges and coping strategies. In: Minhas PS, Rane J, Pasala RK (eds) Abiotic stress management for resilient agriculture. Springer Singapore, Singapore, pp 9–50
Batool M, El-Badri AM, Hassan MU, Yang HY, Wang CY, Yan ZK, Jie K, Wang B, Zhou GS (2023) Drought stress in Brassica napus: effects, tolerance mechanisms, and management strategies. J Plant Growth Regul 42:21–45. https://doi.org/10.1007/s00344-021-10542-9
Battaglia M, Lee C, Thomason W, Fike J, Sadeghpoure A (2019) Hail damage impacts on corn productivity: a review. Crop Sci 59:1–14. https://doi.org/10.2135/cropsci2018.04.0285
Brown S, Nicholls RJ, Lázár AN, Hornby DD, Hill C, Hazra S, Addo KA, Haque A, Caesar J, Tompkins EL (2018) What are the implications of sea-level rise for a 1.5, 2 and 3°C rise in global mean temperatures in the Ganges-Brahmaputra-Meghna and other vulnerable deltas? Reg Environ Change 18:1829–1842. https://doi.org/10.1007/s10113-018-1311-0
Cachat E, Barker M, Read TD, Priest FG (2008) A Bacillus thuringiensis strain producing a polyglutamate capsule resembling that of Bacillus anthracis. FEMS Microbiol Lett 285:220–226. https://doi.org/10.1111/j.1574-6968.2008.01231.x
Candela T, Moya M, Haustant M, Fouet A (2009) Fusobacterium nucleatum, the first Gram-negative bacterium demonstrated to produce polyglutamate. Can J Microbiol 55:627–632. https://doi.org/10.1139/W09-003
Cao M, Geng W, Liu L, Song CJ, Xie H, Guo WB, Jin YH (2011) Glutamic acid independent production of poly-γ-glutamic acid by Bacillus amyloliquefaciens LL3 and cloning of pgsBCA genes. Bioresour Technol 102:4251–4257. https://doi.org/10.1016/j.biortech.2010.12.065
Chandwani S, Amaresan N (2022) Role of ACC deaminase producing bacteria for abiotic stress management and sustainable agriculture production. Environ Sci Pollut Res 29:22843–22859. https://doi.org/10.1007/s11356-022-18745-7
Grant OM (2012) Understanding and exploiting the impact of drought stress on plant physiology. In: Ahmad P, Prasad MNV (eds) Abiotic stress responses in plants. Springer New York, New York, NY, pp 89–104. https://doi.org/10.1007/978-1-4614-0634-1_5
Gupta A, Rico-Medina A, Caño-Delgado AI (2020) The physiology of plant responses to drought. Science 368:266–269. https://doi.org/10.1126/science
Hafez EM, Seleiman MF (2017) Response of barley quality traits, yield and antioxidant enzymes to water-stress and chemical inducers. Int J Plant Prod 11:477–490. https://doi.org/10.22069/ijpp.2017.3712
Haichar FEZ, Cernava T, Liu J, Timm CM (2021) Editorial: novel insights in to the response of the plant microbiome to abiotic factors. Front Plant Sci 12:607874. https://doi.org/10.3389/fpls.2021.607874
Honma M, Shimomura T (1978) Metabolism of 1-aminocyclopropane-1-carboxylic Acid. Agric Biol Chem 42:1825–1831. https://doi.org/10.1080/00021369.1978.10863261
Kambourova M, Tangney M, Priest FG (2001) Regulation of polyglutamic acid synthesis by glutamate in Bacillus licheniformis and Bacillus subtilis. Appl Environ Microbiol 67:1004–1007. https://doi.org/10.1128/AEM.67.2.1004-1007.2001
Katiyar P, Dubey RC, Maheshwari DK (2021) ACC deaminase-producing Ensifer adhaerens KS23 enhances proximate nutrient of Pisum sativum L. cultivated in high altitude. Arch Microbiol 203:2689–2698. https://doi.org/10.1007/s00203-021-02250-5
Kaur G, Asthir B (2017) Molecular responses to drought stress in plants. Biol plant 61:201–209. https://doi.org/10.1007/s10535-016-0700-9
Kunioka M, Goto A (1994) Biosynthesis of poly (γ-glutamic acid) from l-glutamic acid, citric acid, and ammonium sulfate in Bacillus subtilis IFO3335. Appl Microbiol Biotechnol 40:867–872. https://doi.org/10.1007/BF00173990
Martínez-Vilalta J, Garcia‐Forner N (2017) Water potential regulation, stomatal behaviour and hydraulic transport under drought: deconstructing the iso/anisohydric concept. Plant Cell Environ 40:962–976. https://doi.org/10.1111/pce.12846
Maxton A, Singh P, Masih SA (2018) ACC deaminase-producing bacteria mediated drought and salt tolerance in Capsicum annuum. J Plant Nutr 41:574–583. https://doi.org/10.1080/01904167.2017.1392574
Meerak J, Iida H, Watanabe Y, Miyashita M, Sato H, Nakagawa Y (2007) Phylogeny of γ-polyglutamic acid-producing Bacillus strains isolated from fermented soybean foods manufactured in Asian countries. J Gen Appl Microbiol 53:315–323. https://doi.org/10.2323/jgam.53.315
Michel BE, Kaufmann MR (1973) The osmotic potential of polyethylene glycol 6000. Plant Physiol 51:914–916. https://doi.org/10.1104/pp.51.5.914
Moraes L, Brito P, Alegre R (2013) The existing studies on biosynthesis of poly (γ-glutamic acid) by fermentation. Food Public Health Sci Acad Publishing 3:28–36. https://doi.org/10.5923/j.fph.20130301.04
Nagai T, Koguchi K, Itoh Y (1997) Chemical analysis of poly-.GAMMA.-glutamic acid produced by plasmid-free Bacillus subtilis (natto): Evidence that plasmids are not involved in poly-GAMMA-glutamic acid production. J Gen Appl Microbiol 43:139–143. https://doi.org/10.2323/jgam.43.139
O’Brien AM, Ginnan NA, Rebolleda-Gómez M, Wagner MR (2021) Microbial effects on plant phenology and fitness. Am J Bot 108:1824–1837. https://doi.org/10.1002/ajb2.1743
Ogunleye A, Bhat A, Irorere VU, Ding S, Chen GG, Liang ZQ, Zeng W (2015) Poly-γ-glutamic acid: production, properties and applications. Microbiology 161:1–17. https://doi.org/10.1099/mic.0.081448-0
Patil C, Suryawanshi R, Koli S, Patil S (2016) Improved method for effective screening of ACC (1-aminocyclopropane-1-carboxylate) deaminase producing microorganisms. J Microbiol Methods 131:102–104. https://doi.org/10.1016/j.mimet.2016.10.009
Penrose DM, Glick BR (2003) Methods for isolating and characterizing ACC deaminase-containing plant growth‐promoting rhizobacteria. Physiol Plant 118:10–15. https://doi.org/10.1034/j.1399-3054.2003.00086.x
Remke MJ, Johnson NC, Bowker MA (2022) Sympatric soil biota mitigate a warmer-drier climate for Bouteloua gracilis. Glob Change Biol 28:6280–6292. https://doi.org/10.1111/gcb.16369
Roberson EB, Firestone MK (1992) Relationship between desiccation and exopolysaccharide production in a soil pseudomonas sp. Appl Environ Microbiol 58:1284–1291. https://doi.org/10.1128/aem.58.4.1284-1291.1992
Sandhya VZAS, SK ZA, Grover M, Reddy G, Venkateswarlu B (2009) Alleviation of drought stress effects in sunflower seedlings by the exopolysaccharides producing Pseudomonas putida strain GAP-P45. Biol Fertil Soils 46:17–26. https://doi.org/10.1007/s00374-009-0401-z
Seleiman MF, Al-Suhaibani N, Ali N, Akmal Md, Alotaibi M, Refay Y, Dindaroglu T, Abdul-Wajid HH, Battaglia ML (2021) Drought stress impacts on plants and different approaches to alleviate its adverse effects. Plants 10:259. https://doi.org/10.3390/plants10020259
Setlow B, Atluri S, Kitchel R, Koziol-Dube K, Setlow P (2006) Role of dipicolinic acid in resistance and stability of spores of Bacillus subtilis with or without DNA-protective alpha/beta-type small acid-soluble proteins. J Bacteriol 188:3740–3747. https://doi.org/10.1128/JB.00212-06
Tamura K, Stecher G, Kumar S (2021) MEGA11: molecular evolutionary genetics analysis version 11. Mol Biol Evol 38:3022–3027. https://doi.org/10.1093/molbev/msab120
Warner K, Afifi T (2014) Where the rain falls: Evidence from 8 countries on how vulnerable households use migration to manage the risk of rainfall variability and food insecurity. Climate Dev 6:1–17. https://doi.org/10.1080/17565529.2013.835707
Yandigeri MS, Meena KK, Singh D, Malviya N, Singh DP, Solanki MK, Yadav AK, Arora DK (2012) Drought-tolerant endophytic actinobacteria promote growth of wheat (Triticum aestivum) under water stress conditions. Plant Growth Regul 68:411–420. https://doi.org/10.1007/s10725-012-9730-2
Yao J, Jing J, Xu H, Liang JF, Wu Q, Feng XH, Ouyang PK (2009) Investigation on enzymatic degradation of γ-polyglutamic acid from Bacillus subtilis NX-2. J Mol Catal B: Enzymatic 56:158–164. https://doi.org/10.1016/j.molcatb.2007.12.027
Yoon SH, Do JH, Lee SY, Chang HN (2000) Production of poly-γ-glutamic acid by fed-batch culture of Bacillus licheniformis. Biotechnol Lett 22:585–588. https://doi.org/10.1023/A:1005625026623
Zarei T, Moradi A, Kazemeini SA, Rahi AA (2020) The role of ACC deaminase producing bacteria in improving sweet corn (Zea mays L. var saccharata) productivity under limited availability of irrigation water. Sci Rep 10:20361. https://doi.org/10.1038/s41598-020-77305-6
Zhang S, Gan Y, Xu B (2019) Mechanisms of the IAA and ACC-deaminase producing strain of Trichoderma longibrachiatum T6 in enhancing wheat seedling tolerance to NaCl stress. BMC Plant Biol 19:22. https://doi.org/10.1186/s12870-018-1618-5
Zhang X, Li H, Guo Y, Ding S, Chen GG, Liang ZQ, Zeng W (2021) An integrated strategy for recovery and purification of poly-γ-glutamic acid from fermentation broth and its techno-economic analysis. Sep Purif Technol 278:119575. https://doi.org/10.1016/j.seppur.2021.119575
Sudarshna, & Sharma, N. (2024). Endophytic bacteria associated with critically endangered medicinal plant Trillium govanianum (Wall ex. Royle) and their potential in soil nutrition alleviation. Plant Stress, 11, 100349 https://doi.org/10.1016/j.stress.2024.100349
Author Information
School of Life Sciences, Kavayitri Bahinabai Chaudhari North Maharashtra University, Jalgaon, India